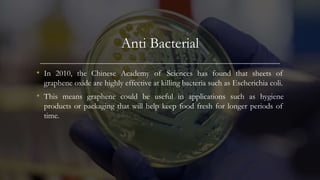
Anti Bacterial
• In 2010, the Chinese Academy of Sciences has found that sheets of
graphene oxide are highly effective at killing bacteria such as Escherichia coli.
• This means graphene could be useful in applications such as hygiene
products or packaging that will help keep food fresh for longer periods of
time.

This document discusses graphene, a one-atom thick material known for its exceptional strength and numerous applications in fields such as electronics, medicine, and energy storage. It covers the history of nanotechnology, various properties and synthesis methods of graphene, and highlights its potential in industries like biomedical applications, integrated circuits, and renewable energy sources. The document concludes by emphasizing graphene's significant advantages despite some drawbacks.